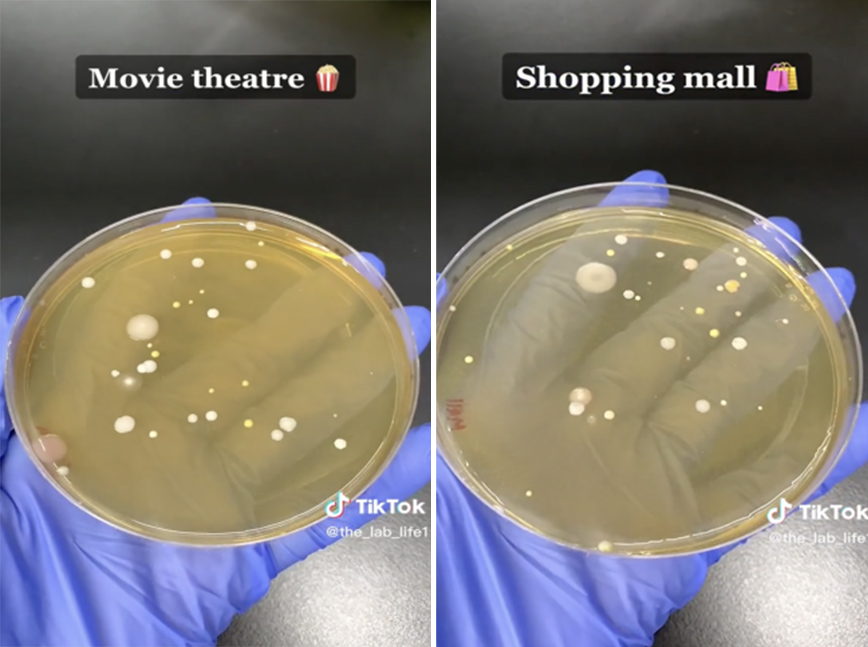

Την επόμενη φορά που θα βρεθείτε σε δημόσιες τουαλέτες, σκεφτείτε το ξανά πριν στεγνώσετε τα χέρια σας στα ειδικά μηχανήματα. Γιατί ένα video το οποίο έγινε viral στο TikTok αποδεικνύει για ακόμη μια φορά πως οι στεγνωτήρες δεν είναι ο πιο υγιεινός τρόπος. Και μάλιστα, μπορούν να πολλαπλασιάσουν και τα βακτήρια!
Ο λογαριασμός @the_lab_life1, δοκίμασε τρεις διαφορετικούς στεγνωτήρες, σε τρία διαφορετικά σημεία για να διαπιστώσει τον αριθμό των βακτηρίων τα οποία σπρώχνονται μέσω του ζεστού αέρα προς τα χέρια μας.
Τα αποτελέσματα έγιναν viral καθώς το video έχει προβληθεί ήδη 26 εκατομμύρια φορές και η συντριπτική πλειοψηφία των θεατών συμφώνησαν πως θα σταματήσουν να χρησιμοποιούν τους στεγνωτήρες.
Δείτε το video:
Κάθε στεγνωτήρας και η μέθοδος λειτουργίας του, φέρνουν διαφορετικά αποτελέσματα, τα οποία ωστόσο είναι όλα ανθυγιεινά.
«Δεν μπορώ να πω ότι είμαι εντελώς σοκαρισμένη από τον αριθμό των βακτηρίων, αλλά από τους διαφορετικούς τύπους. Νόμιζα πως θα έβρισκα βακτήρια που συναντάμε συχνά αλλά υπάρχουν τόσα διαφορετικά», ανέφερε η χρήστρια που έκανε το τεστ.
Το πρόβλημα με τους στεγνωτήρες είναι πως χρειάζονται διαρκώς συντήρηση και καθαρισμό. Κάθε εγκατάσταση που τους διαθέτει, έχει διαφορετικά πρωτόκολλα καθαρισμού και συντήρησης, κάτι το οποίο ουσιαστικά τους μετατρέπει σε αποικίες βακτηρίων.
Μάλιστα, έρευνα του 2018 από το πανεπιστήμιο του Κονέκτικατ είχε εντοπίσει βακτήρια που συναντούμε σε ακαθαρσίες, στα χέρια όσων χρησιμοποιούσαν στεγνωτήρες!